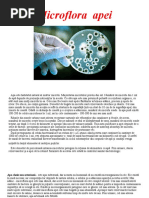

0% au considerat acest document util (0 voturi)
172 vizualizări9 paginiCastelul Bran
Încărcat de
Ludmila BeregoiDrepturi de autor
© © All Rights Reserved
Respectăm cu strictețe drepturile privind conținutul. Dacă suspectați că acesta este conținutul dumneavoastră, reclamați-l aici.
Formate disponibile
Descărcați ca PPTX, PDF, TXT sau citiți online pe Scribd
0% au considerat acest document util (0 voturi)
172 vizualizări9 paginiCastelul Bran
Încărcat de
Ludmila BeregoiDrepturi de autor
© © All Rights Reserved
Respectăm cu strictețe drepturile privind conținutul. Dacă suspectați că acesta este conținutul dumneavoastră, reclamați-l aici.
Formate disponibile
Descărcați ca PPTX, PDF, TXT sau citiți online pe Scribd